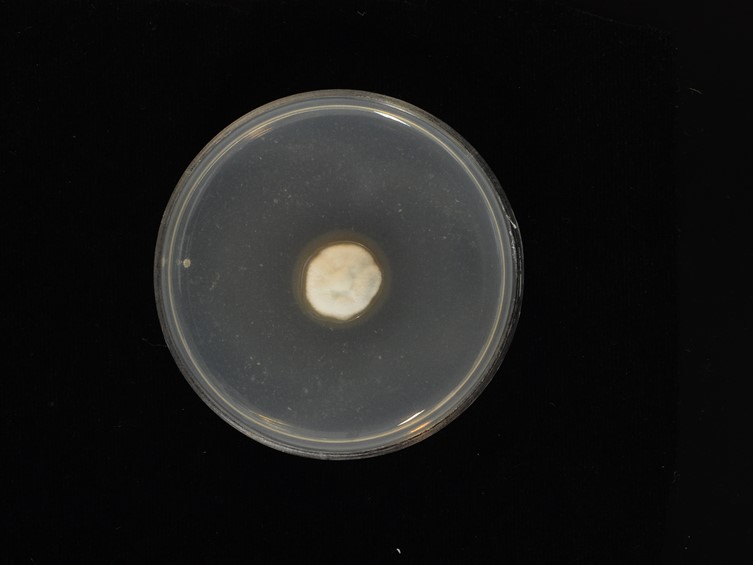

Holotype:
THAILAND, Phitsanulok Province, Banphao Thai Community Forest, 30 May 2017, S. Mongkolsamrit, W. Noisripoom, S. Lamlertthon, W. Pooissarakul, S. Pumiputikul, W. Guntang, S. Khao-ngam, holotype BBH 43164, ex-type living culture TBRC 8502.
Habitat:
Buried in the soil.
Host:
On larva of Elateridae (Coleoptera).
Description:
 Stromata arising from prothorax and abdomen of Elateridae larva (Coleoptera).
Stromata arising from prothorax and abdomen of Elateridae larva (Coleoptera).  Fertile head globose to subglobose, 2-4 × 2-5 mm, grayish yellow when fresh, light brown when dry. Stipe cream to light brown when dry, inside hollow, 2-3.5 cm long, 1.5-2.5 mm wide.
Fertile head globose to subglobose, 2-4 × 2-5 mm, grayish yellow when fresh, light brown when dry. Stipe cream to light brown when dry, inside hollow, 2-3.5 cm long, 1.5-2.5 mm wide.  Perithecia obclavate, completely immersed, 650-800 × 160-250 μm.
Perithecia obclavate, completely immersed, 650-800 × 160-250 μm.  Asci hyaline, cylindrical, eight-spored, up to 480 μm long, 5-6 μm wide.
Asci hyaline, cylindrical, eight-spored, up to 480 μm long, 5-6 μm wide.  Ascospores hyaline, filiform, multi-septate, breaking into 64 cylindrical part-spores, 5-10 × 1-2 μm.
Ascospores hyaline, filiform, multi-septate, breaking into 64 cylindrical part-spores, 5-10 × 1-2 μm.
Culture characteristics:
Colony on PDA in 30 d at 25°C approximately 1 cm diam, white, colonies reverse pale brown. Mycelium smooth-walled, septate, hyaline. Conidiogenous cells phialidic, cylindrical, swollen at the base or slightly flaskshaped, in whorls of 2–4, 10–18 × 2–4 μm, with distinct phialide necks, 4–8 × 1–1.5 μm. Conidia hyaline, smooth, aseptate, distinctly of two types, mostly cylindrical, 7–10 × 2 μm, fusiform, 3–6 × 1 μm.
Colony on PDA in 30 d at 25°C approximately 1 cm diam, white, colonies reverse pale brown. Mycelium smooth-walled, septate, hyaline. Conidiogenous cells phialidic, cylindrical, swollen at the base or slightly flaskshaped, in whorls of 2–4, 10–18 × 2–4 μm, with distinct phialide necks, 4–8 × 1–1.5 μm. Conidia hyaline, smooth, aseptate, distinctly of two types, mostly cylindrical, 7–10 × 2 μm, fusiform, 3–6 × 1 μm.
Reference:
Mongkolsamrit S, Noisripoom W, Arnamnart N, et al. (2019). Resurrection of Paraisaria in the Ophiocordycipitaceae with three new species from Thailand. Mycological Progress 18: 1213–1230.
DOI: https://doi.org/10.1007/s11557-019-01518-xSpecies |
Strain |
Compound |
Pubchem CID |
Biological activity |
Reference |
|---|
|
Strain |
ITS | LSU | RPB1 | TEF1 |
|---|---|---|---|---|
| BBH 43163 | MH188539 | MK332584 | MH211349 | MH211353 |
| TBRC 8502 | MH188540 | MH201168 | MH211350 | MH211354 |